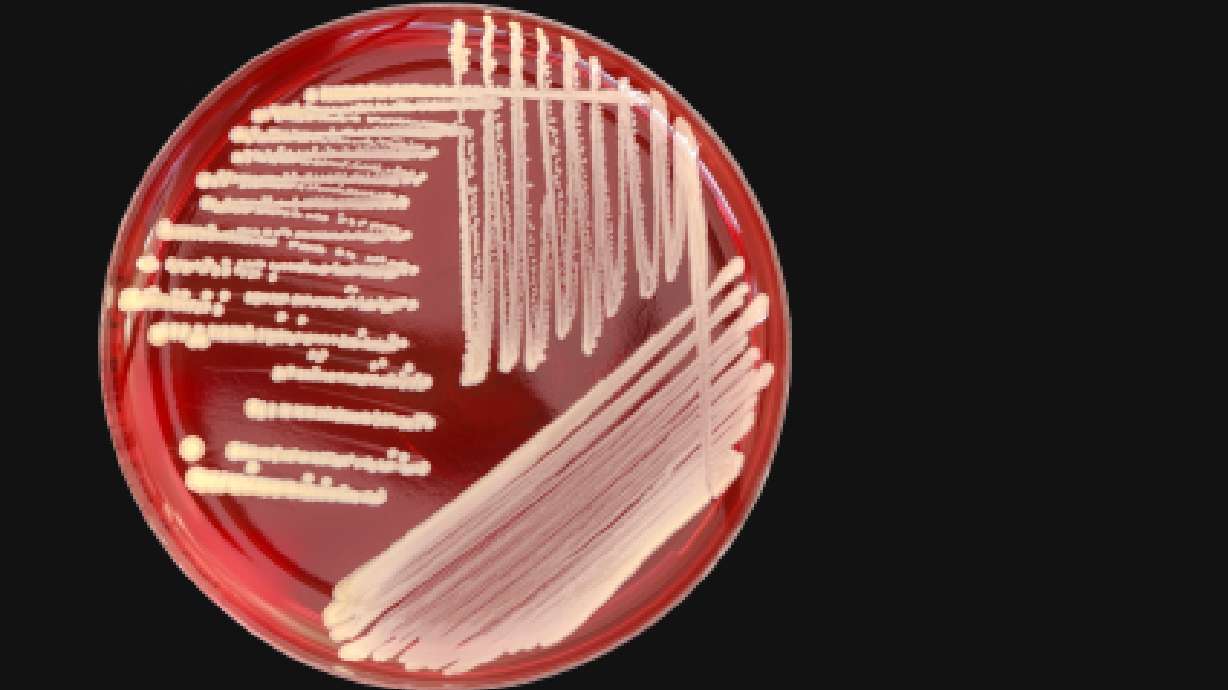
Mercy from MRSA

Estimated read time: 1-2 minutes
This archived news story is available only for your personal, non-commercial use. Information in the story may be outdated or superseded by additional information. Reading or replaying the story in its archived form does not constitute a republication of the story.
It's time now for some good news about our fight against a serious health threat. Hi, I'm Dr. Cindy Haines, host of HealthDay TV. In recent years, a type of bacteria that has gotten a lot of attention in the media is Staphylococcus aureus, especially kinds that have become resistant to an antibiotic called methicillin. These are called MRSA, for short. Infections from MRSA can be fatal, and people can develop them in hospitals and other health care facilities.
In today's issue of the Journal of the American Medical Association, researchers measured recent trends in MRSA infections associated with health-care settings. They looked at infections occurring in nine areas of the country.
From 2005 through 2008, the rate of invasive MRSA infections that appeared to begin in the hospital fell more than 9 percent each year. The rate of MRSA infections that appeared to develop outside the hospital - but may have been linked to a health-care setting - fell by nearly 6 percent each year.
To help reduce your risk of the skin infections that MRSA can also cause, the Centers for Disease Control and Prevention recommend that you: clean and cover all cuts and scrapes on your skin; wash your hands regularly; and avoid sharing personal items like razors.